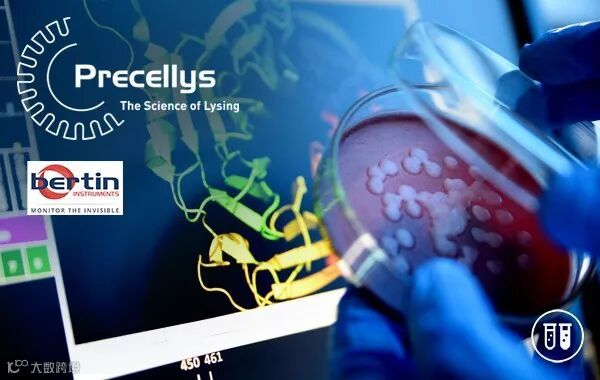

“获得高质量和高产率的蛋白质对于质谱和色谱等精密分析应用至关重要。选择合适的原料用量、正确的裂解试剂盒和有效的研磨方案是保证最佳结果的关键。”
Martin Serrano Sanchez
应用科学家

Bertin新的生物试剂BCA和Bradford比色法适用于96WP格式和2mL管。

利用Precellys Evolution和 Cryolys Evolution优化蛋白提取
>>灵活性: 24 x 2mL (或 0.5mL), 12 x 7mL, 6 x 15mL 研磨管和 96 孔板
>>高效性: up to 10 000 rpm ,可研磨任何类型的样品
>>保护性: Cryolys 冷却器保护你的生物分子
推荐阅读
>>祝贺法国Bertin Precellys获得SelectScience产品品质银奖
>>利用Precellys / Cryolys Evolution开发深度冷冻生物样品研磨的新应用
>>Precellys Evolution:微生物组提取无偏差DNA
>>研磨界冷却系统世界杯冠军:Bertin Cryolys Evolution
>>Bertin研磨仪应用:从心肌组织小样本中分离提取肌原纤维
>>Bertin研磨仪新应用:快速获得单细胞悬液,流式分析好助手
>>Bertin Precellys应用方案:植物与动物基因组制备
>>高通量组织研磨仪PRECELLYS EVOLUTION 96孔板裂解试剂盒
>>Precellys应用:海洋样品制备的最佳做法
>>Bertin+ZYMO强强联合:1分钟内破碎微生物提取DNA
>>Bertin Precellys应用案例:从蜱虫提取RNA
>>Bertin Precellys应用案例:从大鼠皮肤组织提取蛋白质沉淀与油脂
>>Bertin Precellys应用案例:从皮肤组织中提取RNA
>>严正声明:伯齐科技将严厉打击违规销售法国Bertin产品行为
>>Bertin 发布新型研磨冷却器: Cryolys® Evolution
>>Bertin Precellys研磨应用手册:研磨活细胞或病毒提取DNA/RNA
>>Bertin Precellys研磨器:牡蛎DNA提取解决方案
>>法国Bertin发布Precellys Evolution骨骼/牙齿直磨方案
>>2000多篇期刊和应用向您推荐法国Bertin Precellys生物样品研磨器
欢迎关注伯齐官方微信(微信公众号:Bio-Gene)
回复:bertin,查看相关视频
长按以下二维码可识别关注公众号

伯齐科技有限公司
Bio-Gene Technology Ltd.
广州伯齐生物科技有限公司
热线:176 2009 3784
www.bio-gene.com.cn
marketing@bio-gene.com.cn

